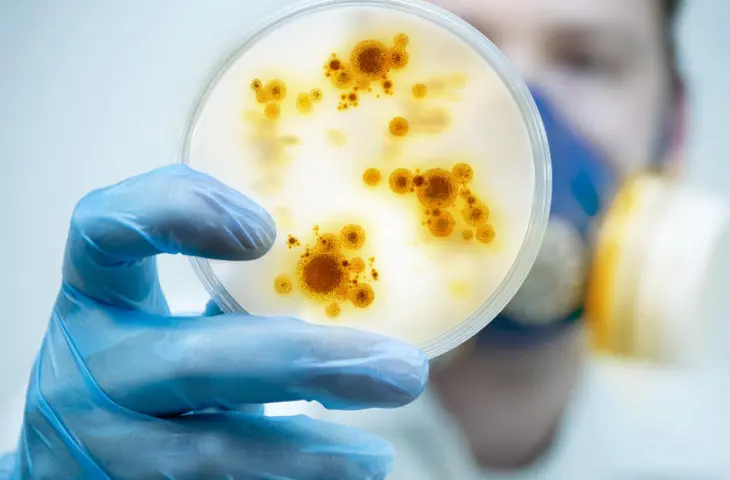

Le service Elis Pest Control inclut :
-
Audit de vos locaux et récapitulatif des implantations
-
Mise en place ciblée sur notre site + classeur HACCP
-
Traçabilité de toutes nos interventions
-
Conseils et recommandations
-
Rapport d’intervention envoyé systématiquement
Micro-nuisibles
Elis propose des traitements bactéricides, fongicides et virucides. Les protocoles sont adaptés en fonction du secteur d’activité du client et de la spécificité de ses locaux.
Il s’agit de traitements de pulvérisation ou de nébulisation avec des produits professionnels, les modes opératoires permettent de vous apporter un service de qualité conciliant sécurité et efficacité.
Un service soucieux de son impact environnemental
L’impact environnemental est au cœur de nos préoccupations ; nous basons nos interventions sur la méthode de lutte intégrée est basée sur l'adoption de techniques et de solutions innovantes plus respectueuses de l’environnement.
Cela implique un diagnostic systématique de votre établissement qui permet :
- d’adapter nos prestations à votre secteur d’activité
- d’opter pour des solutions non-toxiques en fonction du nuisible ciblé
Renseignement, devis ou demande d’intervention
Elis assure une traçabilité systématique d'intervention grâce à Elis Connect

Besoin d'une information ? Contactez-nous !
*Champs obligatoires
Détails de votre compte








